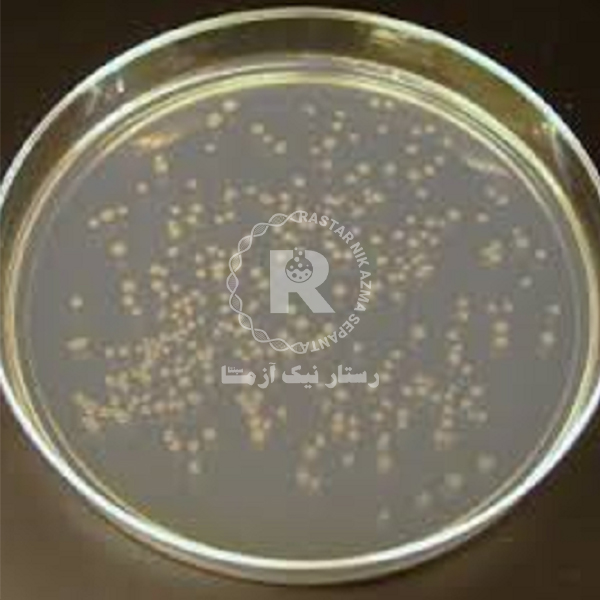
نوترينت آگار 500gr كيولب

مشخصات محصول:
محیط کشت نوترینت آگار (NUTRIENT AGAR) برای کشت باکتری هایی که سخت پسند نیستند و همچنین برای شمارش ارگانیسم های موجود در آب و فاضلاب، مدفوع و دیگر نمونه ها قابل استفاده است. باکتری های رشد کرده در محیط بصورت کلنی در سطح محیط قابل مشاهده است.
ویژگی محیط کشت نوترینت آگار (NUTRIENT AGAR) کیولب
- در دماهای بالا جامد است
- نوعی محیط کشت عمومی است
- pH خنثی در دمای 25 درجه سانتی گراد
- دارای مواد مغذی لازم جهت رشد میکروارگانیسم ها
کاربرد محیط کشت نوترینت آگار (NUTRIENT AGAR) کیولب
- تکثیر میکروارگانیسم هایی نیاز به شرایط سخت محیطی ندارند.
نظرات دوستان